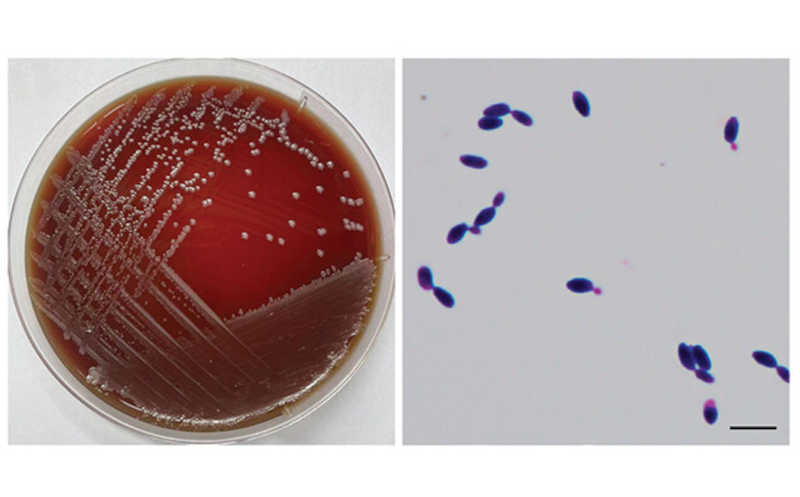

Микологияx
COVID-19 Медицина Секвенирование Вирусология Онкология Диагностика Неврология Молбиология Бактериология Иммунная система Et сetera Экспрессия генов Эпидемиология Клинические исследования et сetera Молекулярная диагностика Вакцины Биоинформатика Клеточная биология Терапия Новые препараты Геномика Генетика Метаболизм Технологии Мероприятия Государственное регулирование Образование Биомаркеры Рынок и регулирование Российские компании Новые концепции Иммунотерапия Обзоры периодики Наследственные заболевания Фарма Сердечно-сосудистые заболевания PCR Методология эксперимента Иммунологические методы Редактирование генома Репродуктивное здоровье Организация науки Новые инструменты и оборудование Инвестиции Генная терапия Эпигенетика Избранное CRISPR Протеомика Финансирование исследований Бизнес-среда Утренний кофе Тест-системы в клинике Гастроэнтерология Долголетие и старение Паразитология Персонализированная медицина Подготовка образцов Рынок клинической диагностики Интервью Микрочипы и мультиплексный анализ crispr Масс-спектрометрия Древняя и историческая ДНК Анализ единичных клеток Российские новости Сопроводительная диагностика Вебинары Ветеринария Органоиды pcr Метафаза МД-2023 МД-2025 МД-2021 Работа в биотехе Амплификация нуклеиновых кислот Поможем друг другу! Вопросы и ответы Рейтинги ИФА Синтетическая биология Анализ единичных клеткок День ДНК 2023 Подготовка об covid-19 Направления Репродуктивное здор Курсы Государственное регулиров (Не)простые вопросы Все
Предыдущая
Следующая


 Меню
Меню





 Все темы
Все темы